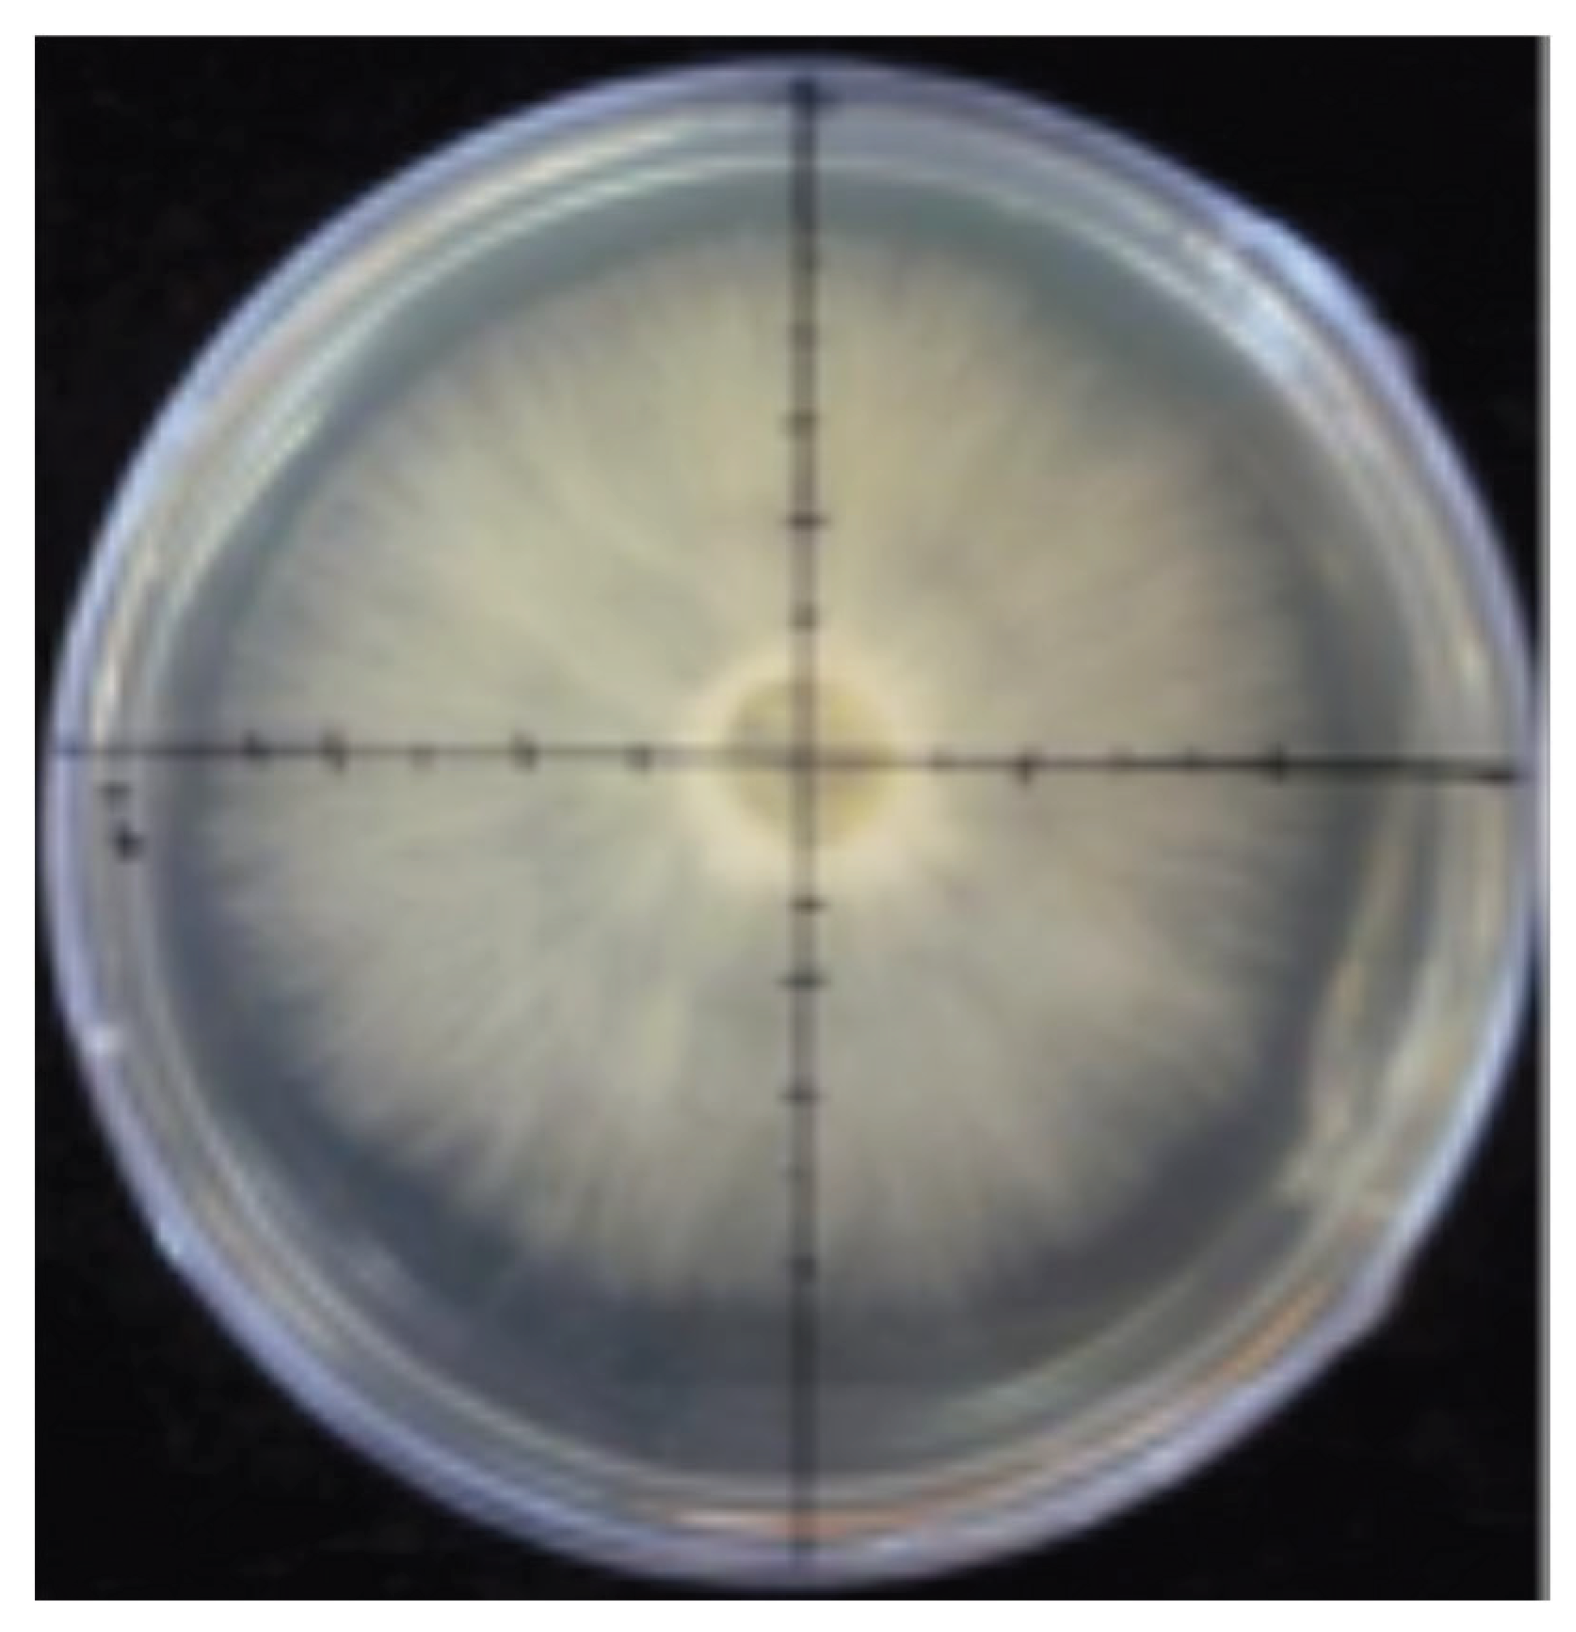
Preprints 190144 g002

Submitted:
16 December 2025
Posted:
09 January 2026
You are already at the latest version
Abstract
Keywords:
Introduction
Methodology
Collection of Fruiting Bodies
Culture In Vitro
Production of Pleurotus dejamour and Hericium erinaceus in Residual Substrates
Strains
Preparation of Inoculum in Agar
Preparation of Inoculant Seed Treatments

Substrates for Fungal Growth
Inoculation and Incubation on Final Substrate

Results
| SPECIES | FAMILY | EDIBILITY | LIFE FORM |
|---|---|---|---|
| Ascomycetes | |||
| Chlorociboria aeruginascens (Nyl.) Kanouse. | Chlorociboriaceae | S | |
| Calycina citrina (Hedw.) Gray. | Pezizellaceae | S | |
| Bulgaria inquinans (Pers.) Fr. | Phacidiaceae | S | |
| Leotia lubrica (Scop.) Pers. | Leotiaceae | S | |
| Cudonia circinans (Pers.) Fr. | Cudoniaceae | S | |
| Spathularia flavida Pers. | Cudoniaceae | S | |
| Gyromitra esculenta Pers. ex Fr. | Discinaceae | E | S |
| Paragyromitra infula (Schaeff.) X.C. Wang & W.Y. Zhuang. | Discinaceae | S | |
| Helvella acetabulum (L.) Quél. | Helvellaceae | S | |
| Helvella dryophila Vellinga & N.H. Nguye | Helvellaceae | S | |
| Helvella elastica Bull. | Helvellaceae | S | |
| Helvella lacunosa Fr. | Helvellaceae | S | |
| Helvella macropus (Pers.) P. Karst. | Helvellaceae | S | |
| Morchella conica Krombh. | Morchellaceae | E | M |
| Morchella sp. | Morchellaceae | M | |
| Otidea onotica (Pers.) Fuckel. | Otideaceae | S | |
| Peziza vesiculosa Pers. | Pezizaceae | S | |
| Sarcosphaera coronaria (Jacq.) J. Schröt. | Pezizaceae | S | |
| Aleuria aurantia (Pers.) Fuckel. | Pyronemataceae | S | |
| Humaria hemisphaerica (F.H. Wigg.) Fuckel. | Pyronemataceae | S | |
| Scutellinia scutellata (L.) Lambotte. | Pyronemataceae | S | |
| Phillipsia sp. | Sarcoscyphaceae | S | |
| Phillipsia domingensis (Berk.) Berk. ex Denison. | Sarcoscyphaceae | S | |
| Sarcoscypha coccinea (Scop.) Sacc. ex E.J. Durand. | Sarcoscyphaceae | S | |
| Sarcoscypha occidentalis (Schwein.) Sacc. | Sarcoscyphaceae | S | |
| Cordyceps militaris (L.) Fr. | Cordycipitaceae | M | P |
| Hypomyces chrysospermus Tul. & C. Tul. | Hypocreaceae | P | |
| Hypomyces hyalinus (Schwein.) Tul. & C. Tul. | Hypocreaceae | P | |
| Hypomyces lactifluorum (Schwein.) Tul. & C. Tul. | Hypocreaceae | E | P |
| Hypomyces sp. | Hypocreaceae | P | |
| Tolypocladium capitatum (Holmsk.) C.A. Quandt, Kepler & Spatafora. | Ophiocordycipitaceae | P | |
| Biscogniauxia atropunctata (Schwein.) Pouzar. | Graphostromataceae | P | |
| Annulohypoxylon thouarsianum (Lév.) Y.M. Ju, J.D. Rogers & H.M. Hsieh. | Hypoxylaceae | P | |
| Daldinia childiae J.D. Rogers & Y.M. Ju. | Hypoxylaceae | ||
| Hypoxylon fragiforme (Pers.) J. Kickx f. | Hypoxylaceae | ||
| Ustulina deusta (Hoffm.) Maire | Xylariaceae | P | |
| Xylaria hypoxylon (L.) Grev. | Xylariaceae | P | |
| Xylosphaera poitei (Lév.) Dennis. | Xylariaceae | P | |
| Xylaria polymorpha (Pers.) Grev. | Xylariaceae | P | |
| Xylaria titan Berk. & M.A. Curtis. | Xylariaceae | P | |
| Trichoglossum hirsutum (Pers.) Boud. | Geoglossaceae | S | |
| Basidiomycetes | |||
| Dacrymyces chrysospermus Berk. & M.A. Curtis. | Dacrymycetaceae | S | |
| Dacryopinax spathularia (Schwein.) G.W. Martin. | Dacrymycetaceae | S | |
| Myxarium nucleatum Wallr. | Hyaloriaceae | S | |
| Phaeotremella foliacea (Pers.) Wedin, J.C. Zamora & Millanes. | Tremellaceae | S | |
| Tremella fuciformis Berk. | Tremellaceae | S | |
| Tremella mesenterica (Schaeff.) Pers. | Tremellaceae | S | |
| Asproinocybe sp. | Agaricaceae | M | |
| Baeospora myosura (Fr.) Singer. | Agaricaceae | S | |
| Clitocybe fragrans (With.) P. Kumm. | Agaricaceae | S | |
| Clitocybe sordida Velen. | Agaricaceae | S | |
| Crucibulum laeve (Huds.) Kambly. | Agaricaceae | S | |
| Cyathus olla (Batsch) Pers. | Agaricaceae | S | |
| Cyathus stercoreus (Schwein.) De Toni. | Agaricaceae | S | |
| Cyathus striatus Willd. | Agaricaceae | S | |
| Cystodermella cinnabarina (Alb. & Schwein.) Harmaja. | Agaricaceae | S | |
| Cystoderma amianthinum (Scop.) Fayod. | Agaricaceae | S | |
| Cystodermella granulosa (Batsch) Harmaja. | Agaricaceae | S | |
| Gerronema strombodes (Berk. & Mont.) Singer. | Agaricaceae | S | |
| Infundibulicybe gibba (Pers.) Harmaja. | Agaricaceae | S | |
| Lepista nuda (Bull.) Cooke. | Agaricaceae | S | |
| Leucopholiota decorosa (Peck) O.K. Mill., T.J. Volk & Bessette. | Agaricaceae | S | |
| Melanoleuca cognata (Fr.) Konrad & Maubl. | Agaricaceae | S | |
| Melanoleuca dryophila Murrill. | Agaricaceae | S | |
| Nidula candida (Peck) V.S. White. | Agaricaceae | S | |
| Panaeolina foenisecii (Pers.) Maire. | Agaricaceae | S | |
| Pleurocybella porrigens (Pers.) Singer. | Agaricaceae | S | |
| Tricholomopsis decora (Fr.) Singer. | Agaricales | M | |
| Tricholomopsis rutilans (Schaeff.) Singer. | Agaricales | S | |
| Agaricus arvensis Schaeff. | Agaricaceae | E | S |
| Agaricus augustus Fr. | Agaricaceae | E | S |
| Agaricus campestris L. | Agaricaceae | E | S |
| Agaricus cantharellus Batsch. | Agaricaceae | S | |
| Agaricus hondensis Murrill. | Agaricaceae | S | |
| Agaricus placomyces Peck. | Agaricaceae | S | |
| Agaricus xanthodermus Genev. | Agaricaceae | T | S |
| Battarrea phalloides (Dicks.) Pers. | Agaricaceae | S | |
| Chlorophyllum molybdites (G. Mey.) Massee. | Agaricaceae | T | S |
| Chlorophyllum olivieri (Barla) Vellinga. | Agaricaceae | T | S |
| Chlorophyllum rhacodes (Vittad.) Vellinga. | Agaricaceae | T | S |
| Coprinus comatus (O.F. Müll.) Pers. | Agaricaceae | S | |
| Lepiota cristata (Bolton) P. Kumm. | Agaricaceae | T | S |
| Leucoagaricus leucothites (Vittad.) Wasser. | Agaricaceae | T | S |
| Leucocoprinus birnbaumii (Corda) Singer | Agaricaceae | T | S |
| Leucocoprinus cepistipes (Sowerby) Pat. | Agaricaceae | T | S |
| Leucocoprinus fragilissimus (Ravenel ex Berk. & M.A. Curtis) Pat. | Agaricaceae | S | |
| Leucocoprinus rubrotinctus (Peck) Redhead. | Agaricaceae | S | |
| Macrolepiota procera (Scop.) Singer. | Agaricaceae | E | S |
| Montagnea arenaria (DC.) Zeller. | Agaricaceae | S | |
| Phellorinia herculeana (Pers.) Kreisel. | Agaricaceae | S | |
| Podaxis pistillaris (L.) Fr. | Agaricaceae | E | S |
| Tulostoma pulchellum Sacc. | Agaricaceae | S | |
| T. mohavensis | Agaricaceae | S | |
| Amanita amerivirosa Tulloss, L.V. Kudzma & M. Tulloss. | Amanitaceae | T | M |
| Amanita bisporigera G.F. Atk. | Amanitaceae | T | M |
| Amanita calyptroderma G.F. Atk. & V.G. Ballen. | Amanitaceae | E | M |
| Amanita flavoconia G.F. Atk. | Amanitaceae | T | M |
| Amanita flavorubescens G.F. Atk. | Amanitaceae | T | M |
| Amanita fulva Fr. | Amanitaceae | T | M |
| Amanita jacksonii Pomerl. | Amanitaceae | E | M |
| Amanita magniverrucata Thiers & Ammirati | Amanitaceae | T | M |
| Amanita muscaria (L.) Lam. | Amanitaceae | T | M |
| Amanita novinupta Tulloss & J. Lindgr. | Amanitaceae | T | M |
| Amanita pantherina (DC.) Krombh. | Amanitaceae | T | M |
| Amanita phalloides (Vaill. ex Fr.) Link. | Amanitaceae | T | M |
| Amanita rubescens Pers. | Amanitaceae | T | M |
| Amanita smithiana Bas. | Amanitaceae | T | M |
| Amanita spreta (Peck) Sacc. | Amanitaceae | T | M |
| Amanita vaginata (Bull.) Lam. | Amanitaceae | T | M |
| Amanita velosa (Peck) Lloyd. | Amanitaceae | T | M |
| Bolbitius titubans (Bull.) Fr. | Bolbitiaceae | T | S |
| Conocybe apala (Fr.) Arnolds. | Bolbitiaceae | T | S |
| Conocybe tenera (Schaeff.) Kühner. | Bolbitiaceae | T | S |
| Clavaria fragilis Holmsk. | Clavariaceae | S | |
| Clavulinopsis fusiformis (Sowerby) Corner. | Clavariaceae | S | |
| Ramariopsis kunzei (Fr.) Corner. | Clavariaceae | S | |
| Collybia nuda (Bull.) Z.M. He & Zhu L. Yang | Clitocybaceae | S | |
| Cortinarius armillatus (Fr.) Fr. | Cortinariaceae | T | M |
| Cortinarius caperatus (Pers.) Fr. | Cortinariaceae | T | M |
| Cortinarius cinnamomeus (L.) Gray. | Cortinariaceae | T | M |
| Cortinarius corrugatus Peck. | Cortinariaceae | T | M |
| Cortinarius iodes Berk. & M.A. Curtis. | Cortinariaceae | T | M |
| Cortinarius semisanguineus (Fr.) Gillet. | Cortinariaceae | T | M |
| Cortinarius traganus (Fr.) Fr. | Cortinariaceae | T | M |
| Cortinarius violaceus (L.) Gray. | Cortinariaceae | T | M |
| Phlegmacium glaucopus (Schaeff.) Wünsche. | Cortinariaceae | T | M |
| Crepidotus crocophyllus (Berk.) Sacc. | Crepidotaceae | S | |
| Crepidotus mollis (Schaeff.) Staude. | Crepidotaceae | S | |
| Chondrostereum purpureum (Pers.) Pouzar. | Cyphellaceae | S | |
| Clitopilus prunulus (Scop.) P. Kumm. | Entolomataceae | S | |
| Entoloma sp. | Entolomataceae | S | |
| Entoloma sericeum Quél. | Entolomataceae | S | |
| Entoloma rhodopolium (Fr.) P. Kumm. | Entolomataceae | S | |
| Entoloma velutinum Hesler. | Entolomataceae | S | |
| Panaeolus antillarum (Fr.) Dennis. | Galeropsidaceae | S | |
| Panaeolus cinctulus (Bolton) Sacc. | Galeropsidaceae | S | |
| Panaeolus papilionaceus (Bull.) Quél. | Galeropsidaceae | S | |
| Laccaria sp. | Hydnangiaceae | M | |
| Laccaria amethystina Cooke. | Hydnangiaceae | M | |
| Laccaria bicolor (Maire) P.D. Orton. | Hydnangiaceae | E | M |
| Laccaria laccata (Scop.) Cooke. | Hydnangiaceae | E | M |
| Laccaria ochropurpurea (Berk.) Peck. | Hydnangiaceae | M | |
| Arrhenia sp. | Hygrophoraceae | T | S |
| Arrhenia epichysium (Pers.) Redhead, Lutzoni, Moncalvo & Vilgalys. | Hygrophoraceae | T | S |
| Cuphophyllus colemannianus (A. Bloxam) Bon. | Hygrophoraceae | S | |
| Cuphophyllus pratensis (Pers.) Bon. | Hygrophoraceae | S | |
| Cuphophyllus virgineus (Wulfen) Kovalenko. | Hygrophoraceae | S | |
| Gliophorus psittacinus (Schaeff.) Herink. | Hygrophoraceae | S | |
| Hygrocybe cantharellus (Schwein.) Murrill. | Hygrophoraceae | S | |
| Hygrocybe coccinea (Schaeff.) P. Kumm. | Hygrophoraceae | S | |
| Hygrocybe conica (Schaeff.) P. Kumm. | Hygrophoraceae | S | |
| Hygrocybe flavescens (Kauffman) Singer. | Hygrophoraceae | S | |
| Hygrocybe miniata (Fr.) P. Kumm. | Hygrophoraceae | S | |
| Hygrophorus chrysodon (Batsch) Fr. | Hygrophoraceae | S | |
| Hygrophorus eburneus (Bull.) Fr. | Hygrophoraceae | S | |
| Hygrophorus erubescens (Fr.) Fr. | Hygrophoraceae | S | |
| Hygrophorus pudorinus (Fr.) Fr. | Hygrophoraceae | S | |
| Hygrophorus russula (Schaeff. ex Fr.) Bataille | Hygrophoraceae | S | |
| Lichenomphalia umbellifera (L.) Redhead, Lutzoni, Moncalvo & Vilgalys, | Hygrophoraceae | S | |
| Galerina marginata (Batsch) Kühner. | Hymenogastraceae | T | S |
| Gymnopilus luteofolius (Peck) Singer. | Hymenogastraceae | H | S |
| Gymnopilus sapineus (Fr.) Murrill. | Hymenogastraceae | S | |
| Psilocybe coronilla (Bull.) Noordel. | Hymenogastraceae | H | S |
| Psilocybe cyanescens Wakef. | Hymenogastraceae | H | S |
| Psilocybe semilanceata (Fr.) P. Kumm. | Hymenogastraceae | H | S |
| Inosperma calamistratum (Fr.) Matheny & Esteve-Rav. | Inocybaceae | T | M |
| Inocybe geophylla P. Kumm. | Inocybaceae | T | M |
| Inocybe hystrix (Fr.) P. Karst. | Inocybaceae | T | M |
| Pseudosperma sororium (Kauffman) Matheny & Esteve-Rav. | Inocybaceae | T | M |
| Apioperdon pyriforme (Schaeff.) Vizzini. | Lycoperdaceae | S | |
| Bovista plumbea Pers. | Lycoperdaceae | S | |
| Calbovista subsculpta Morse ex M.T. Seidl. | Lycoperdaceae | S | |
| Calvatia cyathiformis (Bosc) Morgan. | Lycoperdaceae | E | S |
| Lycoperdon marginatum Vittad. | Lycoperdaceae | S | |
| Lycoperdon perlatum Pers. | Lycoperdaceae | S | |
| Utraria pulcherrima (Berk. & M.A. Curtis) R.L. Zhao & J.Xin Li | Lycoperdaceae | S | |
| Utraria umbrina (Pers.) R.L. Zhao & J.Xin Li | Lycoperdaceae | S | |
| Hypsizygus ulmarius (Bull.) Redhead. | Lyophyllaceae | E | S |
| Lyophyllum decastes (Fr.) Singer. | Lyophyllaceae | E | S |
| Macrocystidia cucumis (Pers.) Joss. | Macrocystidiaceae | S | |
| Marasmius plicatulus Peck. | Marasmiaceae | S | |
| Marasmius rotula (Scop.) Fr. | Marasmiaceae | S | |
| Marasmius siccus (Schwein.) Fr. | Marasmiaceae | S | |
| Tetrapyrgos nigripes (Fr.) E. Horak. | Marasmiaceae | S | |
| Favolaschia sp. | Mycenaceae | S | |
| Hemimycena lactea (Pers.) Singer. | Mycenaceae | S | |
| Mycena acicula (Schaeff.) P. Kumm. | Mycenaceae | S | |
| Mycena amicta (Fr.) Quél. | Mycenaceae | S | |
| Mycena epipterygia (Scop.) Gray. | Mycenaceae | S | |
| Mycena galericulata (Scop.) Gray. | Mycenaceae | S | |
| Mycena leptocephala (Pers.) Gillet. | Mycenaceae | S | |
| Mycena pura (Pers.) P. Kumm. | Mycenaceae | S | |
| Panellus stipticus (Bull.) P. Karst. | Mycenaceae | T, BIO | S |
| Xeromphalina campanella (Batsch) Kühner & Maire. | Mycenaceae | S | |
| Xeromphalina cauticinalis (Fr.) Kühner & Maire. | Mycenaceae | S | |
| Xeromphalina fulvipes (Murrill) A.H. Sm. | Mycenaceae | S | |
| Marasmiellus candidus (Fr.) Singer. | Omphalotaceae | S | |
| Collybiopsis quercophila (Pouzar) R.H. Petersen. | Omphalotaceae | S | |
| Collybiopsis subnuda (Ellis ex Peck) R.H. Petersen. | Omphalotaceae | S | |
| Gymnopus dryophilus (Bull.) Murrill. | Omphalotaceae | S | |
| Mycetinis opacus (Berk. & M.A. Curtis) A.W. Wilson & Desjardin. | Omphalotaceae | S | |
| Omphalotus olivascens H.E. Bigelow, O.K. Mill. & Thiers. | Omphalotaceae | T | P |
| Omphalotus subilludens (Murrill) H.E. Bigelow. | Omphalotaceae | S | |
| Rhodocollybia butyracea (Bull.) Lennox. | Omphalotaceae | S | |
| Rhodocollybia maculata (Alb. & Schwein.) Singer. | Omphalotaceae | S | |
| Phyllotopsis nidulans (Pers.) Singer. | Phyllotopsidaceae | T | S |
| Armillaria mellea (Vahl) P. Kumm. | Physalacriaceae | E | P |
| Desarmillaria tabescens (Scop.) R.A. Koch & Aime. | Physalacriaceae | E, T | P |
| Cyptotrama asprata (Berk.) Redhead & Ginns. | Physalacriaceae | S | |
| Flammulina velutipes (Curtis) Singer. | Physalacriaceae | E | S |
| Hymenopellis furfuracea (Peck) R.H. Petersen. | Physalacriaceae | S | |
| Hymenopellis radicata (Relhan) R.H. Petersen. | Physalacriaceae | S | |
| Strobilurus conigenoides (Ellis) Singer. | Physalacriaceae | S | |
| Strobilurus trullisatus (Murrill) Lennox. | Physalacriaceae | S | |
| Hohenbuehelia angustata (Berk.) Singer. | Pleurotaceae | S | |
| Hohenbuehelia petaloides (Bull.) Schulzer. | Pleurotaceae | S | |
| Pleurotus cornucopiae (Paulet) Quél. | Pleurotaceae | E | S |
| Pleurotus djamor (Rumph. ex Fr.) Boedijn. | Pleurotaceae | E | S |
| Pleurotus dryinus (Pers.) P. Kumm. | Pleurotaceae | E | S |
| Resupinatus alboniger (Pat.) Singer. | Pleurotaceae | S | |
| Resupinatus applicatus (Batsch) Gray. | Pleurotaceae | S | |
| Pluteus americanus (P. Banerjee & Sundb.) Justo, E.F. Malysheva & Minnis. | Pluteaceae | S | |
| Pluteus cervinus (Schaeff.) P. Kumm. | Pluteaceae | S | |
| Pluteus chrysophlebius (Berk. & M.A. Curtis) Sacc. | Pluteaceae | S | |
| Pluteus petasatus (Fr.) Gillet. | Pluteaceae | S | |
| Volvariella bombycina (Schaeff.) Singer. | Pluteaceae | E | S |
| Volvopluteus gloiocephalus (DC.) Vizzini, Contu & Justo. | Pluteaceae | S | |
| Candolleomyces candolleanus (Fr.) D. Wächt. & A. Melzer. | Psathyrellaceae | S | |
| Coprinellus disseminatus (Pers.) J.E. Lange. | Psathyrellaceae | S | |
| Coprinellus domesticus (Bolton) Vilgalys, Hopple & Jacq. Johnson. | Psathyrellaceae | S | |
| Coprinellus micaceus (Bull.) Vilgalys, Hopple & Jacq. Johnson. | Psathyrellaceae | S | |
| Coprinopsis atramentaria (Bull.) Redhead, Vilgalys & Moncalvo. | Psathyrellaceae | S | |
| Coprinopsis lagopides (P. Karst.) Redhead, Vilgalys & Moncalvo. | Psathyrellaceae | S | |
| Coprinopsis lagopus (Fr.) Redhead, Vilgalys & Moncalvo. | Psathyrellaceae | S | |
| Parasola plicatilis (Curtis) Redhead, Vilgalys & Hopple. | Psathyrellaceae | S | |
| Psathyrella bipellis (Quél.) A.H. Sm. | Psathyrellaceae | S | |
| Psathyrella piluliformis (Bull.) P.D. Orton. | Psathyrellaceae | S | |
| Radulomyces sp. | Radulomycetaceae | S | |
| Schizophyllum commune Fr. | Schizophyllaceae | NR | S, P |
| Schizophyllum fasciatum Pat. | Schizophyllaceae | NR | S, P |
| Schizophyllum umbrinum Berk. | Schizophyllaceae | NR | S, P |
| Deconica coprophila (Bull.) P. Karst. | Strophariaceae | T | S |
| Deconica montana (Pers.) P.D. Orton. | Strophariaceae | T | S |
| Hypholoma capnoides (Fr.) P. Kumm. | Strophariaceae | T | S |
| Hypholoma fasciculare (Huds.) P. Kumm. | Strophariaceae | T | S |
| Hypholoma lateritium (Schaeff.) P. Kumm. | Strophariaceae | T | S |
| Pholiota adiposa (Batsch) P. Kumm. | Strophariaceae | T | S |
| Pholiota squarrosa (Vahl) P. Kumm. | Strophariaceae | T | S |
| Pholiota squarrosoides (Peck) Sacc. | Strophariaceae | T | S |
| Protostropharia semiglobata (Batsch) Redhead, Moncalvo & Vilgalys. | Strophariaceae | T | S |
| Stropharia coronilla (Bull.) Quél.. | Strophariaceae | H | S |
| Tapinella atrotomentosa (Batsch) Šutara. | Tapinellaceae | T | S |
| Tapinella panuoides (Fr.) E.-J. Gilbert. | Tapinellaceae | T | S |
| Leucopaxillus albissimus (Peck) Singer. | Tricholomataceae | T | S |
| Leucopaxillus gentianeus (Quél.) Kotl. | Tricholomataceae | T | S |
| Tricholoma caligatum (Viv.) Ricken. | Tricholomataceae | E | M |
| Tricholoma equestre (L.) P. Kumm. | Tricholomataceae | M | |
| Tricholoma murrillianum Singer. | Tricholomataceae | M | |
| Tricholoma sejunctum (Sowerby) Quél. | Tricholomataceae | M | |
| Tricholoma terreum (Schaeff.) P. Kumm. | Tricholomataceae | M | |
| Ductifera pululahuana (Pat.) Donk. | Auriculariaceae | S | |
| Pseudohydnum gelatinosum (Scop.) P. Karst. | Auriculariaceae | S | |
| Baorangia bicolor (Kuntze) G. Wu, Halling & Zhu L. Yang. | Boletaceae | M | |
| Boletellus ananas (M.A. Curtis) Murrill. | Boletaceae | M | |
| Boletus barrowsii Thiers & A.H. Sm. | Boletaceae | E | M |
| Boletus edulis Bull. | Boletaceae | E | M |
| Neoboletus subvelutipes (Peck) Yang Wang, B. Zhang & Yu Li | Boletaceae | M | |
| Exsudoporus frostii (J.L. Russell) Vizzini, Simonini & Gelardi. | Boletaceae | E | M |
| Cyanoboletus pulverulentus (Opat.) Gelardi, Vizzini & Simonini. | Boletaceae | M | |
| Harrya chromipes (Frost) Halling, Nuhn, Osmundson & Manfr. Binder. | Boletaceae | E | M |
| Hortiboletus campestris (A.H. Sm. & Thiers) Biketova & Wasser. | Boletaceae | M | |
| Imleria badia (Fr.) Vizzini. | Boletaceae | M | |
| Leccinellum albellum (Peck) Bresinsky & Manfr. Binder. | Boletaceae | M | |
| Leccinum manzanitae Thiers. | Boletaceae | E | M |
| Leccinum aeneum Halling. | Boletaceae | M | |
| Phylloporus rhodoxanthus (Schwein.) Bres. | Boletaceae | S | |
| Porphyrellus cyaneotinctus (A.H. SM. & Thiers) Singer | Boletaceae | M | |
| Pulchroboletus rubricitrinus (Murrill) Farid & A.R. Franck. | Boletaceae | M | |
| Pulveroboletus ravenelii (Berk. & M.A. Curtis) Murrill. | Boletaceae | M | |
| Retiboletus griseus (Frost) Manfr. Binder & Bresinsky. | Boletaceae | M | |
| Rubroboletus eastwoodiae (Murrill) Vasquez, Simonini, Svetash., Mikšík & Vizzini. | Boletaceae | M | |
| Strobilomyces strobilaceus (Scop.) Berk. | Boletaceae | M | |
| Sutorius eximius (Peck) Halling, Nuhn & Osmundson. | Boletaceae | M | |
| Tylopilus felleus (Bull.) P. Karst. | Boletaceae | T | M |
| Tylopilus plumbeoviolaceus (Snell & E.A. Dick) Snell & E.A. Dick. | Boletaceae | M | |
| Tylopilus tabacinus (Peck) Singer. | Boletaceae | M | |
| Xerocomellus carmeniae Garza-Ocañas, J. García & de la Fuente. | Boletaceae | M | |
| Xerocomellus diffractus N. Siegel, C.F. Schwarz & J.L. Frank. | Boletaceae | M | |
| Xerocomus subtomentosus (L.) Quél. | Boletaceae | M | |
| Boletinellus merulioides (Schwein.) Murrill. | Boletinellaceae | E | S,M |
| Boletinellus rompelii (Pat. & Rick) Watling | Boletinellaceae | E | S,M |
| Calostoma cinnabarinum Desv. | Calostomataceae | S | |
| Astraeus hygrometricus (Pers.) Morgan. | Diplocystidiaceae | M | |
| Astraeus pteridis (Shear) Zeller. | Diplocystidiaceae | M | |
| Gomphidius roseus (Fr.) Oudem. | Gomphidiaceae | M | |
| Gyroporus castaneus (Bull.) Quél. | Gyroporaceae | E | M |
| Hygrophoropsis aurantiaca (Wulfen) Maire ex Martin-Sans. | Hygrophoropsidaceae | S | |
| Melanogaster variegatus (Vittad.) Tul. & C. Tul. | Paxillaceae | E | M |
| Rhizopogon sp. | Rhizopogonaceae | M | |
| Rhizopogon occidentalis Zeller & C.W. Dodge. | Rhizopogonaceae | E | M |
| Pisolithus arhizus (Scop.) Rauschert. | Sclerodermataceae | M | |
| Scleroderma areolatum Ehrenb. | Sclerodermataceae | T | M |
| Scleroderma cepa Pers. | Sclerodermataceae | T | M |
| Scleroderma citrinum Pers. | Sclerodermataceae | T | M |
| Scleroderma texense Berk. | Sclerodermataceae | T | M |
| Scleroderma verrucosum (Bull.) Pers. | Sclerodermataceae | T | M |
| Serpula himantioides (Fr.) P. Karst. | Serpulaceae | P | |
| Suillus americanus (Peck) Snell. | Suillaceae | M | |
| Suillus lakei (Murrill) A.H. Sm. & Thiers. | Suillaceae | M | |
| Suillus spraguei (Berk. & M.A. Curtis) Kuntze. | Suillaceae | M | |
| Suillus tomentosus Singer, Snell & E.A. Dick. | Suillaceae | E | M |
| Cantharellus cibarius Fr. | Hydnaceae | E | M |
| Cantharellus cinnabarinus (Schwein.) Schwein. | Hydnaceae | E | M |
| Cantharellus lateritius (Berk.) Singer. | Hydnaceae | E | M |
| Cantharellus minor Peck. | Hydnaceae | E | M |
| Craterellus cornucopioides (L.) Pers. | Hydnaceae | E | M |
| Craterellus ignicolor (R.H. Petersen) Dahlman, Danell & Spatafora. | Hydnaceae | E | M |
| Hericium erinaceus (Bull) Pers. | Hericiaceae | E | S,M |
| Hydnum albidum Peck. | Hydnaceae | E | M |
| Hydnum repandum L. | Hydnaceae | E | M |
| Geastrum floriforme Vittad. | Geastraceae | S | |
| Geastrum minimum Schwein. | Geastraceae | S | |
| Myriostoma coliforme (Dicks.) Corda. | Geastraceae | S | |
| Gloeophyllum sp. | Gloeophyllaceae | P | |
| Gloeophyllum sepiarium (Wulfen) P. Karst. | Gloeophyllaceae | P | |
| Heliocybe sulcata (Berk.) Redhead & Ginns. | Gloeophyllaceae | S | |
| Neolentinus lepideus (Fr.) Redhead & Ginns. | Gloeophyllaceae | S | |
| Gomphus clavatus (Pers.) Gray. | Gomphaceae | M | |
| Turbinellus floccosus (Schwein.) Earle ex Giachini & Castellano. | Gomphaceae | M | |
| Pallidohirschioporus biformis (Fr.) Y.C. Dai, Yuan Yuan & M. Zhou | Hirschioporaceae | P | |
| Fuscoporia gilva (Schwein.) T. Wagner & M. Fisch. | Hymenochaetaceae | P | |
| Hydnoporia olivacea (Schwein.) Teixeira. | Hymenochaetaceae | P | |
| Inonotus hispidus (Bull.) P. Karst. | Hymenochaetaceae | P | |
| Fulvifomes robiniae (Murrill) Murrill | Hymenochaetaceae | P | |
| Pseudoinonotus dryadeus (Pers.) T. Wagner & M. Fisch. | Hymenochaetaceae | P | |
| Trichaptum biforme (Fr.) Ryvarden. | Hymenochaetales | P | |
| Contumyces rosellus (M.M. Moser) Redhead, Moncalvo, Vilgalys & Lutzoni. | Rickenellaceae | P | |
| Lysurus mokusin (L. f.) Fr. | Phallaceae | S | |
| Climacocystis borealis (Fr.) Kotl. & Pouzar. | Polyporales | S | |
| Fabisporus sanguineus (L.) Zmitr. | Polyporales | S | |
| Cerrena hydnoides (Sw.) Zmitr. | Cerrenaceae | S | |
| Cerrena unicolor (Bull.) Murrill. | Cerrenaceae | S | |
| Jahnoporus hirtus (Cooke) Nuss. | Dacryobolaceae | S | |
| Postia ptychogaster (F. Ludw.) Vesterh. | Dacryobolaceae | S | |
| Daedalea quercina (L.) Pers. | Fomitopsidaceae | P | |
| Rhodofomes cajanderi (P. Karst.) B.K. Cui, M.L. Han & Y.C. Dai | Fomitopsidaceae | P | |
| Byssomerulius corium (Pers.) Parmasto. | Irpicaceae | S | |
| Byssomerulius incarnatus (Schwein.) Gilb. | Irpicaceae | S | |
| Irpex lacteus (Fr.) Fr. | Irpicaceae | S | |
| Leptoporus mollis (Pers.) Quél. | Irpicaceae | S | |
| Vitreoporus dichrous (Fr.) Zmitr. | Irpicaceae | S | |
| Ischnoderma resinosum (Schrad.) P. Karst. | Ischnodermataceae | P | |
| Phaeolus schweinitzii (Fr.) Pat. | Laetiporaceae | P | |
| Irpiciporus pachyodon (Pers.) Kotl. & Pouzar. | Meruliaceae | P | |
| Phlebia radiata Fr. | Meruliaceae | S | |
| Phlebia tremellosa (Schrad.) Nakasone & Burds. | Meruliaceae | S | |
| Panus conchatus (Bull.) Fr. | Panaceae | S | |
| Panus strigellus (Berk.) Chardón & Toro. | Panaceae | S | |
| Hapalopilus rutilans (Pers.) Murrill. | Phanerochaetaceae | P | |
| Terana coerulea (Lam.) Pers. | Phanerochaetaceae | S | |
| Abortiporus biennis (Bull.) Singer. | Podoscyphaceae | P | |
| Cryptoporus volvatus (Peck) Shear. | Polyporaceae | P | |
| Cubamyces lactineus (Berk.) Lücking. | Polyporaceae | P | |
| Cyanosporus caesius (Schrad.) McGinty. | Polyporaceae | P | |
| Daedaleopsis confragosa (Bolton) J. Schröt. | Polyporaceae | P | |
| Favolus tenuiculus P. Beauv. | Polyporaceae | E | S |
| Fomes fasciatus (Sw.) Cooke. | Polyporaceae | P | |
| Ganoderma applanatum (Pers.) Pat. | Polyporaceae | M | P |
| Ganoderma curtisii (Berk.) Murrill. | Polyporaceae | M | P |
| Lentinus arcularius (Batsch) Zmitr. | Polyporaceae | M | S |
| Lentinus crinitus (L.) Fr. | Polyporaceae | S | |
| Lentinus tigrinus (Bull.) Fr. | Polyporaceae | S | |
| Lentinus tricholoma (Mont.) Zmitr. | Polyporaceae | S | |
| Lenzites betulinus (L.) Fr. | Polyporaceae | P | |
| Neofavolus alveolaris (DC.) Sotome & T. Hatt. | Polyporaceae | S | |
| Picipes badius (Pers.) Zmitr. & Kovalenko. | Polyporaceae | S | |
| Polyporus umbellatus (Pers.) Fr. | Polyporaceae | S | |
| Trametes gibbosa (Pers.) Fr. | Polyporaceae | P | |
| Trametes hirsuta (Wulfen) Lloyd. | Polyporaceae | S | |
| Trametes versicolor (L.) Lloyd. | Polyporaceae | M | S |
| Sparassis radicata Weir. | Sparassidaceae | E | P |
| Steccherinum ochraceum (Pers. ex J.F. Gmel.) Gray. | Steccherinaceae | S | |
| Gymnosporangium juniperi-virginianae Schwein. | Gymnosporangiaceae | P | |
| Albatrellopsis ellisii (Berk. ex Cooke & Ellis) Teixeira. | Albatrellaceae | E | S |
| Albatrellopsis flettii (Morse ex Pouzar) Audet. | Albatrellaceae | S | |
| Albatrellus ovinus (Schaeff.) Kotl. & Pouzar. | Albatrellaceae | S | |
| Artomyces pyxidatus (Pers.) Jülich. | Auriscalpiaceae | S | |
| Auriscalpium vulgare Gray. | Auriscalpiaceae | S | |
| Lentinellus ursinus (Fr.) Kühner. | Auriscalpiaceae | S | |
| Bondarzewia sp. | Bondarzewiaceae | P | |
| Bondarzewia berkeleyi (Fr.) Bondartsev & Singer. | Bondarzewiaceae | P | |
| Heterobasidion annosum (Fr.) Bref. | Bondarzewiaceae | P | |
| Heterobasidion occidentale Otrosina & Garbel. | Bondarzewiaceae | P | |
| Peniophora albobadia (Schwein.) Boidin. | Peniophoraceae | S | |
| Lactarius argillaceifolius Hesler & A.H. Sm. | Russulaceae | M | |
| Lactifluus corrugis (Peck) Kuntze. | Russulaceae | M | |
| Laeticutis cristata (Schaeff.) Audet. | Russulales | M | |
| Lactarius deliciosus (L.) Gray. | Russulaceae | E | M |
| Lactarius indigo (Schwein.) Fr. | Russulaceae | E | M |
| Lactarius paradoxus Beardslee & Burl. | Russulaceae | M | |
| Lactifluus piperatus (L.) Roussel. | Russulaceae | T | M |
| Lactarius subplinthogalus Coker. | Russulaceae | M | |
| Lactifluus volemus (Fr.) Kuntze. | Russulaceae | E | M |
| Neoalbatrellus subcaeruleoporus Audet & B.S. Luther. | Russulales | S | |
| Russula adusta (Pers.) Fr. | Russulaceae | M | |
| Russula brevipes Peck. | Russulaceae | E | M |
| Russula cyanoxantha (Schaeff.) Fr. | Russulaceae | E | M |
| Russula emetica (Schaeff.) Pers. | Russulaceae | M | |
| Russula flavida Frost ex Peck. | Russulaceae | M | |
| Russula fragrantissima Romagn. | Russulaceae | M | |
| Russula mariae Peck. | Russulaceae | M | |
| Russula parvovirescens Buyck, D. Mitch. & Parrent. | Russulaceae | M | |
| Russula xerampelina (Schaeff.) Fr. | Russulaceae | M | |
| Stereum hirsutum (Willd.) Pers. | Stereaceae | S | |
| Stereum lobatum (Kunze ex Fr.) Fr. | Stereaceae | S | |
| Xylobolus frustulatus (Pers.) P. Karst. | Stereaceae | S | |
| Sebacina schweinitzii (Peck) Oberw. | Sebacinaceae | S | |
| Helvellosebacina concrescens (Schwein.) Oberw., Garnica & K. Riess. | Sebacinaceae | S | |
| Hydnellum spongiosipes (Peck) Pouzar. | Bankeraceae | S | |
| Sarcodon imbricatus (L.) P. Karst. | Bankeraceae | S | |
| Phellodon atratus K.A. Harrison. | Thelephoraceae | S | |
| Polyozellus multiplex (Underw.) Murrill. | Thelephoraceae | S | |
| Thelephora palmata (Scop.) Fr. | Thelephoraceae | M | |
| Thelephora terrestris Ehrh. ex Fr. | Thelephoraceae | M |


Growth In Vitro of Selected Species from Nuevo Leon

| Species | Family | Habit | Growth in vitro (cm) x week |
|---|---|---|---|
|
Agaricaceae | S | 3.5 |
|
Agaricaceae | S | 2.1 |
|
Agaricaceae | S | 2.4 |
|
Agaricaceae | S | 1.2 |
|
Amanitaceae | M | 9.5 |
|
Physalacriaceae | M | 0.9 |
|
Auriculariaceae | P | 1.3 |
|
Auriscalpiaceae | S | 2.3 |
|
Hydnaceae | M | 2.3 |
|
Hydnaceae | M | 2.3 |
|
Hydnaceae | M | 3.4 |
|
Omphalotaceae | S | 0.3 |
|
Omphalotaceae | S | 4.3 |
|
Agaricaceae | S | 4 |
|
Agaricaceae | S | 3.4 |
|
Agaricaceae | S | 9 |
|
Psathyrellaceae | S | 0.7 |
|
Polyporaceae | S | 4.3 |
|
Cortinariaceae | M | 0.4 |
|
Agaricaceae | S | 3.9 |
|
Fomitopsidaceae | P | 1.9 |
|
Fomitopsidaceae | S | 2.5 |
|
Entolomataceae | S | 2.4 |
|
Hericiaceae | S | 2 |
|
Hericiaceae | S | 2.1 |
|
Hericiaceae | S | 0.9 |
|
Hericiaceae | S | 1.7 |
|
Hericiaceae | S | 6 |
|
Physalacriaceae | S | 2.3 |
|
Physalacriaceae | S | 1.3 |
|
Polyporaceae | P | 2.2 |
|
Fomitopsidaceae | P | 7.5 |
|
Fomitopsidaceae | P | 2.3 |
|
Polyporaceae | P | 5.4 |
|
Polyporaceae | P | 6.1 |
|
Polyporaceae | P | 1.8 |
|
Polyporaceae | P | 1.5 |
|
Polyporaceae | P | 3.7 |
|
Polyporaceae | P | 2.3 |
|
Polyporaceae | P | 2.4 |
|
Polyporaceae | P | 6.9 |
|
Polyporaceae | S | 3.9 |
|
Polyporaceae | S | 1.3 |
|
Polyporaceae | S | 3.4 |
|
Gloeophyllaceae | P | 6.4 |
|
Hymenogastraceae | S | 3.7 |
|
Hymenogastraceae | S | 4.6 |
|
Hymenogastraceae | S | 3.5 |
|
Stereaceae | S | 2 |
|
Schizoporaceae | S | 0.8 |
|
Hypocreaceae | P | 1.9 |
|
Hymenochaetaceae | P | 1.8 |
|
Hymenochaetaceae | P | 5.5 |
|
Hydnangiaceae | M | 9.6 |
|
Hydnangiaceae | M | 9.8 |
|
Boletaceae | M | 6.5 |
|
Omphalotaceae | S | 0.6 |
|
Omphalotaceae | S | 0.4 |
|
Gloeophyllaceae | S | 3.5 |
|
Gloeophyllaceae | S | 1.5 |
|
Gloeophyllaceae | S | 2.9 |
|
Gloeophyllaceae | S | 1.7 |
|
Tricholomataceae | M | 3.5 |
|
Phallaceae | S | 0.5 |
|
Phallaceae | S | 1.3 |
|
Phallaceae | S | 0.3 |
|
Strophariaceae | P | 4.7 |
|
Strophariaceae | S | 3.9 |
|
Physalacriaceae | S | 2.8 |
|
Physalacriaceae | S | 1.8 |
|
Polyporaceae | S | 6.3 |
|
Paxillaceae | M | 0.8 |
|
Laetiporaceae | P | 1.6 |
|
Hymenochaetaceae | P | 2.6 |
|
Hymenochaetaceae | P | 2 |
|
Sclerodermataceae | M | 0.08 |
|
Pleurotaceae | S | 1.9 |
|
Pleurotaceae | S | 1.3 |
|
Pleurotaceae | S | 2.5 |
|
Pleurotaceae | S | 4.1 |
|
Pleurotaceae | S | 3.6 |
|
Pleurotaceae | S | 4.1 |
|
Pleurotaceae | S | 6.2 |
|
Pleurotaceae | S | 2.2 |
|
Pleurotaceae | S | 5.1 |
|
Pleurotaceae | S | 3.1 |
|
Pleurotaceae | S | 2.4 |
|
Pluteaceae | S | 2.4 |
|
Polyporaceae | S | 6.5 |
|
Polyporaceae | S | 11.1 |
|
Polyporaceae | S | 14.2 |
|
Polyporaceae | S | 9 |
|
Gelatoporiaceae | S | 5.8 |
|
Dacryobolaceae | S | 7.5 |
|
Polyporaceae | S | 3.5 |
|
Russulaceae | M | 8.4 |
|
Schizophyllaceae | S | 2.5 |
|
Schizophyllaceae | S | 2.3 |
|
Boletaceae | M | 1.6 |
|
Suillaceae | M | 2.6 |
|
Tapinellaceae | S | 0.7 |
|
Thelephoraceae | M | 5.6 |
|
Thelephoraceae | M | 3 |
|
Polyporaceae | S | 5.7 |
|
Polyporaceae | S | 4.7 |
|
Polyporaceae | S | 6 |
|
Polyporaceae | P | 6 |
|
Polyporaceae | P | 5.8 |
|
Polyporaceae | P | 9.8 |
|
Mycenaceae | S | 1.3 |
Growth In Vitro
Pleurotus dejamour
Pleurotus dejamour Strains
Hericium erinaceus

Hericium erinaceus







Fruit Bodies Production of Pleurotus dejamour: Treatment No. 1: Sorghum Straw
Fruit Bodies Production of Pleurotus dejamour in Treatment No. 2: Pasture Straw
Fruit Bodies Production of Pleurotus dejamour in Treatment No. 3: Coffee Husks







Discussion
Conclusions
References
- Anonymous. A mushrooming industry. Food production daily. Europe. 2007. Available online: http://foodproductiondaily.com/news/ng.asp?id=69917-mushrooms-shiitake.
- Claridge, AW; Trappe, JM; Hansen, K. Do fungi have a role as soil stabilizers and remediators after forest fire? Forest Ecology and Management 2009, 257, 1063–1069. [Google Scholar] [CrossRef]
- Chang Shu-Ting & Miles P. G., (1989). Edible mushroom and their cultivation. CRC. Press. pp. 27-40 and pp. 238–275.
- Estrada, E.; Villarreal, J.; Salinas, M.; Cantú, C.; González, H.; Jiménez, J., (2014) Coníferas de Nuevo León, México. Universidad Autónoma de Nuevo León. Facultad de Ciencias Forestales. 145 pp.
- Fergus, C.L.; Fergus, C. (2003). Common edible and poisonous mushrooms of the Northeast. (1st ed.) USA: Stackpole Books.
- Garza, F. Hongos ectomicorrícicos en el estado de Nuevo León. Rev. Mex. Mic. 1986, 2, 197–205. [Google Scholar]
- Garza, L.; Ramirez, X.; Garza, F.; Salinas, M.C.; Waksman, N.; Alcaraz, Y.; Torres, O. Evaluación de la actividad biológica de extractos acuosos de macromicetos del noreste de México. Ciencia UANL 2006, 9, 166–170. [Google Scholar]
- Garza, F.; Quiñónez, M.; Garza, L.; Carrillo, A.; Villalón, H.; González, H.; Valenzuela, R.; Guevara, G.; García, J.; García, M.; (2021) Some edible, toxic and medicinal mushrooms from temperate forests in the north of México. In Advances in macrofungi diversity, ecology and biotechnology. Edited by Kandrikere, R.S., and Deshmukh S. pp.145-198.
- Garza, F.; Quiñónez, M.; Guevara, G.; Carrillo, A.; de la Fuente, J.; García, J. Growth responses of Quercus fusiformis (Fagaceae) to ectomycorrhizal inoculation with Boletus luridellus Austrian. J. Mycol. 2022, 29, 193–202. [Google Scholar]
- Garza, F.; Quiñónez Martínez, M.; Carrillo Parra, A. (2023a) Diversity of Macrofungi in the Forest Ecosystems of the Cumbres National Park In: Garza F. (Ed.), Sustainable Management of Natural Resources. Diversity, Ecology, Taxonomy and Sociology. México, Linares: Springer. pp. 223–246. [CrossRef]
- Garza, F.; Guevara Guerrero, G.; Cuellar Rodríguez, G.; Garza Ocañas, L. (2023b) Diversity of Symbiosis Between Species of Macrofungi and Insects in the Temperate Forest of Iturbide Nuevo León In: Garza, F. (Ed.), Sustainable Management of Natural Resources. Diversity, Ecology, Taxonomy and Sociology. México, Linares: Springer. pp. 183–222. Garza, F., Ed.. [CrossRef]
- García, J.; y Garza, F. Conocimiento de los hongos de la Familia Boletaceae de México. Ciencia UANL 2001, 4, 336–343. [Google Scholar]
- García, J.; Ramírez, Y.; Castillo, S.; Moreno, A. Micofagia por roedores en los bosques templados de Tamaulipas. En Biodiversidad Tamaulipeca 2005, 1, 232–237. [Google Scholar]
- García, J.; Valenzuela, R.; Raymundo, T.; García, L.; Guevara, G.; Garza, F.; Cázares, E.; Ruiz, E. Macrohongos asociados a encinares (Quercus spp.,) en algunas localidades del estado de Tamaulipas, México. En Biodiversidad Tamaulipeca 2014, 2, 103–140. [Google Scholar]
- García, J.; Ayala, O.; Guevara, G.; Garza, G.; de la Fuente, J.I. Tuber mixtecorum (Tuberaceae, Pezizales) a new truffle in the Maculatum clade from Mexico. Phytotaxa 2021, 509, 113–120. Available online: https://www.mapress.com/j/pt/. [CrossRef]
- García, L.; Estrada, E.; Cantú, C.; Jurado, E.; Villarreal, J. Diversidad y conservación de los encinos (Fagaceae) del estado de Tamaulipas. En Biodiversidad Tamaulipeca 2014, 2, 3–14. [Google Scholar]
- González, P.; Garza, L.; Salinas, M.C.; Vera, L.; Garza, F.; Ramírez, X.; Torres, O. Producción de metabolitos antimicrobianos, alcaloides y taninos por Suillus lakei in vitro. Ciencia UANL 2009, XII, 62–70. [Google Scholar]
- Guevara, G.; García, J. Hongos comestibles de Tamaulipas. En Biodiversidad Tamaulipeca 2005, 1, 221–231. [Google Scholar]
- Guevara, G.; Giovanni, M.L.; Garza, F.; Gaitán, R. Mycorrhizal Synthesis of Périgord Black Truffle (Tuber melanosporum) with Mexican Oak Species. Microbiol Biotechnol. Lett. 2022, 50, 40–50. [Google Scholar] [CrossRef]
- Guzmán, G; Mata, G; Salmones, D; Soto, C; Guzmán, L. (1993) El cultivo de los hongos comestibles con especial atención a especies tropicales y subtropicales en esquilmos y residuos agroindustriales. Primera Edición. Instituto Politécnico Nacional. 245pp.
- Guo, W.; Wang, C.; Brunner, I.; Zhou, Y.; Wang, J.; Tang, Q.; Li, M.H. A global synthesis reveals that environmental factors drive the proportion of ectomycorrhizal exploration types. Geoderma 2025, 460, 117430. [Google Scholar] [CrossRef]
- Haro-Luna, M.H.; Guzmán-Dávalos, L.; Ruan-Soto, F. (2025) Cultural Importance of Wild Mushrooms: A Comparative Analysis Between Wixaritari and Mestizo Communities Established in Different Types of Vegetation.
- Hawksworth, D.L. The fungal dimension of biodiversity: magnitude, significance, and conservation. Mycological Research 1991, 95, 641–655. [Google Scholar] [CrossRef]
- Index Fungorum (2025) www.indexfungorum.org. Consultado el 21 octubre de 2024.
- Iordache, V.; Gherghel, F.; Kothe, E. Assessing the effect of disturbances on ectomycorrhiza diversity. International Journal of Environmental Research and Public Health 2009, 6, 414–432. [Google Scholar] [CrossRef] [PubMed]
- Kirk PM, Cannon PF, Minter DW, Stalpers JA (eds) (2008) Ainsworth & bisby’s dictionary of the fungi. CAB International, Wallingford.
- Lodge, D.J.; Ammirati, J.F.; Dell, T.O.; Mueller, G.M. (2004) Terrestrial and lignicolous macrofungi: collecting and describing macrofungi. In: Mueller G, Bills GF, Foster MS (Eds.) Biodiversity of Fungi. Inventory and monitoring methods. Elsevier Academic Press, New York, USA, 1–158.
- Marín, M.A.; Silva, V.; Linares, G.; Castagnino, A.M.; Ticante, J.A. La biodiversidad de los hongos ectomicorricicos y su importancia para la conservación del bosque en la zona poblana del Parque Nacional Malintzi. Estudios en Biodiversidad 2015, 1, 180–195. [Google Scholar]
- Madinaveitia, F.; Solis, A.; Medrano, H.; Quintero, J. (1984). "Project for obtaining microbial proteins and soil improvers from sawdust. Isolation of Trichoderma sp." In the utilization of cellulosic resources in animal feed by Mayra de la Torre. CINVESTAV. 253-258.
- Martínez; Carrera, D. Mushroom biotechnology in tropical America. The International Journal of Mushroom Sciences 2000, 3, 9–20. [Google Scholar]
- Mayett, Y.; Martínez, D.; Sánchez, M.; Macias, A.; Mora, S.; Estrada, A. Consumption of edible mushrooms in developing countries: The case of Mexico. J. Int. Fd & Agribus. Mar. 2006, 18, 151–176. [Google Scholar]
- Ostry, M.E.; Anderson, N.A.; O’Brien, J.G. Field guide to common macrofungi in eastern forests and their ecosystem functions. USDA Forest Service Northern Research Station General Technical Report. NRS- 2011, 79, 1–90. [Google Scholar] [CrossRef]
- Rivera, E.; Garza, F.; Quiroz, H.; Cuéllar, G.; Uvalle, J.I.; Valenzuela, R.; Guevara, G. (2023). Interactions between macrofungi and insects via sporocarps in three types of vegetation of the municipality of Linares, Nuevo León, Mexico. In: Garza, F. (Ed.), Sustainable Management of Natural Resources. Diversity, Ecology, Taxonomy and Sociology. México, Linares: Springer. pp. 223–246. [CrossRef]
- Siegel, N.; y Schwarz, C. (2024). Mushrooms of Cascadia, a comprehensive guide to fungi of the Pacific NorthwestBackcountry Press, Humboldt, California, 575pp.
- Solano Zavala, M.H.; Molinar Monsivais, I.; Reyes Ruvalcaba, D.; Quiñónez Martínez, M.; Enriquez Anchondo, I.D.; Garza-Ocañas, F. (2023) Edible Macromycetes of Chihuahua. In Diversity and Nutritional Properties In: Garza F. (Ed.), Sustainable Management of Natural Resources. Diversity, Ecology, Taxonomy and Sociology. México, Linares: Springer. pp. 131–142. [CrossRef]
- Zak JC & Willig MR (2004). Fungal biodiversity patterns. In: Mueller GM, Bills GF & Foster MS (Eds.), Biodiversity of fungi: Inventory and monitoring methods (pp. 59–75). London, England: Elsevier Academy Press.
- Van Nuland, M.E., Averill, C., Justin D., Stewart, Prylutskyi, O., Corrales, A., van Galen, L.G., 2, Bethan F. Manley, B.F., Qin, C., Lauber, T., Mikryukov, V., Dulia, O., Furci, G., Marín, C., Merlin Sheldrake, M., Weedon, J.T., Peay, K.G., Cornwallis, C.K., Větrovský, T., Kohout, P., Baldrian, P., Tedersoo, L., West, S.A., Crowther, T.W., Kiers, E.T. SPUN Mapping Consortium* & Johan van den Hoogen1,2" 2025. Global hotspots of mycorrhizal fungal richness are poorly protected. Nature 1-27.
- Castillo, D.M., Zanatta, M.T., Garza L., Garza, F., Barbosa, O., Villarreal, J. (2025). Insuline release by Fraction II of aquous extracts of Neolentinus lepideus in healthy and alloxan-induced diabetic rats. Journal of Medicinal Plants Research Vol. 19-(10). p.196-204. December 2025. Article number EFC 33837 4044. [CrossRef]
Disclaimer/Publisher’s Note: The statements, opinions and data contained in all publications are solely those of the individual author(s) and contributor(s) and not of MDPI and/or the editor(s). MDPI and/or the editor(s) disclaim responsibility for any injury to people or property resulting from any ideas, methods, instructions or products referred to in the content. |
© 2026 by the authors. Licensee MDPI, Basel, Switzerland. This article is an open access article distributed under the terms and conditions of the Creative Commons Attribution (CC BY) license (http://creativecommons.org/licenses/by/4.0/).
